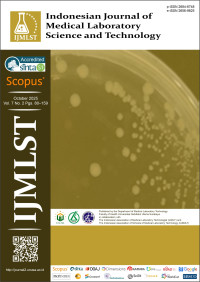
Image of Indonesia journal of medical laboratory science and technology - Vol. 7 No. 2 (2025)

EBOOK TLM
Indonesia journal of medical laboratory science and technology - Vol. 7 No. 2 (2025)
Biomedical research highlights the dual nature of natural compounds: promising therapeutic potential alongside necessary safety considerations. Studies demonstrate Bromelain and Mango seed extracts effectively combat antibiotic-resistant bacteria, while lemongrass-derived diethyl phthalate shows anti-SARS-CoV-2 activity. However, Ciplukan extract reveals organ toxicity at sublethal doses, underscoring the need for safety profiling. Concurrently, STAT3 emerges as a key independent driver in colorectal cancer progression, and environmental toxins like mosquito coil smoke are confirmed to cause emphysema. These findings collectively advocate for an integrated approach in therapeutic development, balancing efficacy with rigorous safety assessment across infectious diseases, oncology, and environmental health.
The articles in this issue were authored/co-authored by authors Malaysia and Indonesia
DOI: https://doi.org/10.33086/ijmlst.v7i2
Published: 2025-10-25
1. In vivo effect of bromelain from Ananas comosus on Staphylococcus aureus skin infection in an animal model
2. Potential of ethanolic extracts from seed kernel Indonesian cultivars mangoes as an anti-multidrug-resistant (MDR) Escherichia coli
3. Effect of subacute toxicity of mosquito coil smoke inhalation on lung histology and blood hematology parameters in Wistar rats
4. Molecular identification and antibacterial activity of endophytic bacteria from Bambusa vulgaris leaves as antibacterial potential against phatogenic microoganism
5. Assessement of Candida albicans of the oral mucosa among type-2 diabetes mellitus patients attending Bahteramas Hospital, Southeast Sulawesi Province
6. In silico approach of antiviral compound from Cymbopongon citratus as the main protease SARS-CoV-2 inhibitor
7. STAT3, but not Ki-67, expression is independently associated with tumor progression in colorectal carcinoma: A comparative immunohistochemical biomarker analysis
8. Acute oral toxicity and dose-dependent histopathological effects of Indonesian Ciplukan (Physalis angulata L.) extract in Sprague-Dawley rats
Ketersediaan
Tidak ada salinan data
Informasi Detail
- Judul Seri
-
-
- No. Panggil
-
-
- Penerbit
- Surabaya : Universitas Nahdlatul Ulama Surabaya., 2025
- Deskripsi Fisik
-
-
- Bahasa
-
English
- ISBN/ISSN
-
2656-9825
- Klasifikasi
-
NONE
- Tipe Isi
-
Jurnal Nasional Online
- Tipe Media
-
Link Internet Online
- Tipe Pembawa
-
-
- Edisi
-
Vol. 7 No. 2 (2025)
- Subjek
-
-
- Info Detail Spesifik
-
-
- Pernyataan Tanggungjawab
-
Universitas Nahdlatul Ulama Surabaya
Versi lain/terkait
Tidak tersedia versi lain
Lampiran Berkas
Komentar
Anda harus masuk sebelum memberikan komentar
 Karya Umum
Karya Umum  Filsafat
Filsafat  Agama
Agama  Ilmu-ilmu Sosial
Ilmu-ilmu Sosial  Bahasa
Bahasa  Ilmu-ilmu Murni
Ilmu-ilmu Murni  Ilmu-ilmu Terapan
Ilmu-ilmu Terapan  Kesenian, Hiburan, dan Olahraga
Kesenian, Hiburan, dan Olahraga  Kesusastraan
Kesusastraan  Geografi dan Sejarah
Geografi dan Sejarah